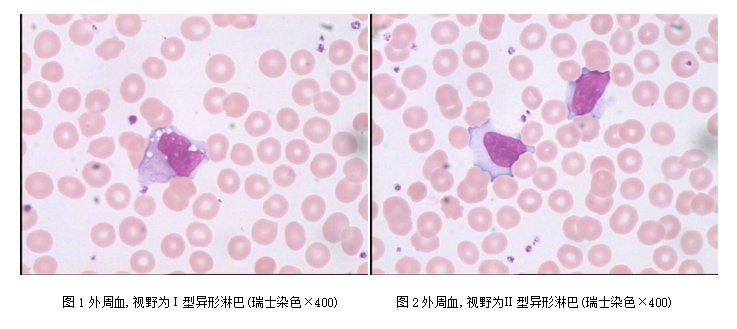

不一样的传染性单核细胞增多综合症——2022科普散文大赛
作者:广东省人民医院 黄美群
【案例经过】
近日,一就诊本院门诊的35岁男性患者,初步诊断是 “胰腺炎”,他血常规检查结果:WBC 12.56×109/L、RBC 4.58×1012/L、Hb 140g/L、PLT 457×109/L,淋巴细胞比值为0.601。人工分类为异形淋巴细胞占55%(图1、2),该细胞胞体大不一,圆形、椭圆形或不规则形,稍偏位,胞浆量多,核周围处较浅,靠胞膜边缘处较深染且不整齐,少数胞浆含有大小不等空泡,有时可有少数散在的紫红色嗜天青颗粒,染色质粗糙呈粗网状或不明显的块状排列。
看到该患者血常规镜下大量异形淋巴细胞(占55%),我产生了疑惑:从血常规结果来看更倾向于传单啊。我马上致电临床医生询问患者病史。临床医生表示该患者出现腹痛、腹泻、呕吐,大便为水样便,尿淀粉酶升高,肝功能出现异常,在发病初期白细胞总数高(13.27×109/L),临床医生考虑胰腺炎可能性大,使用抗菌素治疗后WBC仍高(12.37×109/L),症状无明显好转。
于是,我根据自身经验,与临床医生分析,该患者初期血常规白细胞分类时淋巴细胞比值升高,镜检发现大量异形淋巴(55%),建议医生检查患者巨细胞病毒IgM抗体、血嗜异性凝集试验等,考虑是否是由巨细胞病毒感染引起的传染性单核细胞增多综合症。听完我的分析后,临床医生采纳我的建议。最终检查结果:巨细胞病毒IgM抗体阳性(+),血嗜异性凝集试验阴性,戊肝病毒抗体-IgM阳性。流式细胞检测结果显示:外周血T细胞亚群血中CD3+CD4+(占20.15%) NK(占12.18%)是明显降低,CD3+CD8+(占72.58%)是明显增高,CD4/CD8(0.28:1)比值是明显降低。最终,临床考虑是由巨细胞病毒感染引起的传染性单核细胞增多综合症,对症治疗。
【体会】
传染性单核细胞增多症(简称-IM)是由EB病毒引起的单核-巨噬细胞系统增生性疾病。而传染性单核细胞增多综合症是由巨细胞病毒及其他病毒感染所致的单核-巨噬细胞系统传染病。本病临床症状与传染性单核细胞增多症相类似并表现为复杂多变的临床症状,多发于儿童,成年人比较少见。
本例在发病初期白细胞总数高达13.27×109/L,病人出现腹痛、腹泻、呕吐,大便为水样便,尿淀粉酶升高,肝功能出现异常,症状与胰腺炎比较相似。但该患者初期血常规白细胞分类时淋巴细胞比值是升高,与胰腺炎相反。我们应该加强人工镜检细胞形态学观察,发现异常细胞时及时告知临床医生,为医生的诊治提供有效佐证。
在巨细胞病毒感染的外周血中异型淋巴细胞增高程度一般较低,在小儿,年龄越小,异型淋巴细胞阳性率就越高,而本病是成年人其异型淋巴细胞高达55%。并出现血尿淀粉酶升高、肝功能紊乱及总蛋白、白蛋白降低等严重的临床并发症,这与单纯的传染性单核细胞增多症有着不同之处。
从外周血流式结果分析,CD8+T细胞显著升高,说明巨细胞病毒感染已经使病人的机体免疫系统发生了严重地紊乱,出现了继发性免疫功能低下以及外周血中大量的异形淋巴细胞,致使病人表现复杂的临床症状,但临床上由巨细胞病毒感染出现急性胰腺炎的症状还是比较少见,应引起注意。
